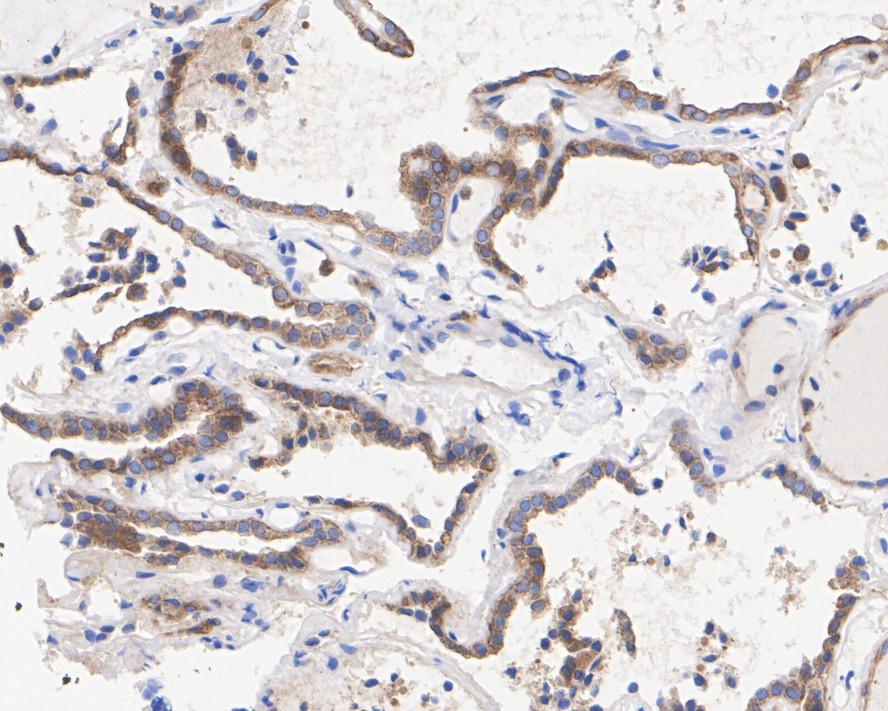
HA722340_2.jpg

EHD1 Recombinant Rabbit Monoclonal Antibody [JE38-59]

cat.: HA722340
| Product Type: | Recombinant Rabbit monoclonal IgG, primary antibodies |
|---|---|
| Species reactivity: | Human, Mouse, Rat |
| Applications: | WB, IHC-P, IP |
| Clonality: | Monoclonal |
| Clone number: | JE38-59 |
| Form: | Liquid |
| Storage condition: | Shipped at 4℃. Store at +4℃ short term (1-2 weeks). Store at -20℃ long term. |
| Storage buffer: | 1*TBS (pH7.4), 0.05% BSA, 40% Glycerol. Preservative: 0.05% Sodium Azide. |
| Concentration: | 1ug/ul |
| Purification: | Protein A affinity purified. |
| Molecular weight: | Predicted band size: 61 kDa |
| Isotype: | IgG |
| Immunogen: | Synthetic peptide within Human EHD1 aa 1-50 / 534. |
| Positive control: | HeLa cell lysate, SK-OV-3 cell lysate, mouse lung tissue lysate, mouse brain tissue lysate, rat lung tissue lysate, rat brain tissue lysate, human thyroid carcinoma tissue, human lung tissue, mouse lung tissue, rat lung tissue. |
| Subcellular location: | Recycling endosome membrane, Early endosome membrane, Cell membrane, Cell projection, cilium membrane. |
| Recommended Dilutions:
WB IHC-P IP |
1:1,000 1:200-1:1,000 1-2μg/sample |
| Uniprot #: | SwissProt: Q9H4M9 Human | Q9WVK4 Mouse | Q641Z6 Rat |
| Alternative names: | CDABP0131 EH domain containing 1 EH domain-containing protein 1 EHD1 EHD1_HUMAN FLJ42622 FLJ44618 H PAST hPAST1 PAST PAST homolog 1 PAST1 Testilin |
Images

|
Fig1:
Western blot analysis of EHD1 on different lysates with Rabbit anti-EHD1 antibody (HA722340) at 1/1,000 dilution. Lane 1: HeLa cell lysate Lane 2: SK-OV-3 cell lysate Lane 3: Mouse lung tissue lysate Lane 4: Mouse brain tissue lysate Lane 5: Rat lung tissue lysate Lane 6: Rat brain tissue lysate Lysates/proteins at 20 µg/Lane. Predicted band size: 61 kDa Observed band size: 61 kDa Exposure time: 12 seconds; ECL: K1801; 4-20% SDS-PAGE gel. Proteins were transferred to a PVDF membrane and blocked with 5% NFDM/TBST for 1 hour at room temperature. The primary antibody (HA722340) at 1/1,000 dilution was used in 5% NFDM/TBST at 4℃ overnight. Goat Anti-Rabbit IgG - HRP Secondary Antibody (HA1001) at 1/50,000 dilution was used for 1 hour at room temperature. |
|
Fig2:
Immunohistochemical analysis of paraffin-embedded human thyroid carcinoma tissue with Rabbit anti-EHD1 antibody (HA722340) at 1/200 dilution. The section was pre-treated using heat mediated antigen retrieval with Tris-EDTA buffer (pH 9.0) for 20 minutes. The tissues were blocked in 1% BSA for 20 minutes at room temperature, washed with ddH2O and PBS, and then probed with the primary antibody (HA722340) at 1/200 dilution for 1 hour at room temperature. The detection was performed using an HRP conjugated compact polymer system. DAB was used as the chromogen. Tissues were counterstained with hematoxylin and mounted with DPX. |

|
Fig3:
Immunohistochemical analysis of paraffin-embedded human lung tissue with Rabbit anti-EHD1 antibody (HA722340) at 1/200 dilution. The section was pre-treated using heat mediated antigen retrieval with Tris-EDTA buffer (pH 9.0) for 20 minutes. The tissues were blocked in 1% BSA for 20 minutes at room temperature, washed with ddH2O and PBS, and then probed with the primary antibody (HA722340) at 1/200 dilution for 1 hour at room temperature. The detection was performed using an HRP conjugated compact polymer system. DAB was used as the chromogen. Tissues were counterstained with hematoxylin and mounted with DPX. |

|
Fig4:
Immunohistochemical analysis of paraffin-embedded mouse lung tissue with Rabbit anti-EHD1 antibody (HA722340) at 1/1,000 dilution. The section was pre-treated using heat mediated antigen retrieval with Tris-EDTA buffer (pH 9.0) for 20 minutes. The tissues were blocked in 1% BSA for 20 minutes at room temperature, washed with ddH2O and PBS, and then probed with the primary antibody (HA722340) at 1/1,000 dilution for 1 hour at room temperature. The detection was performed using an HRP conjugated compact polymer system. DAB was used as the chromogen. Tissues were counterstained with hematoxylin and mounted with DPX. |

|
Fig5:
Immunohistochemical analysis of paraffin-embedded rat lung tissue with Rabbit anti-EHD1 antibody (HA722340) at 1/1,000 dilution. The section was pre-treated using heat mediated antigen retrieval with Tris-EDTA buffer (pH 9.0) for 20 minutes. The tissues were blocked in 1% BSA for 20 minutes at room temperature, washed with ddH2O and PBS, and then probed with the primary antibody (HA722340) at 1/1,000 dilution for 1 hour at room temperature. The detection was performed using an HRP conjugated compact polymer system. DAB was used as the chromogen. Tissues were counterstained with hematoxylin and mounted with DPX. |

|
Fig6:
EHD1 was immunoprecipitated from 0.2 mg HeLa cell lysate with HA722340 at 2 µg/10 µl beads. Western blot was performed from the immunoprecipitate using HA722340 at 1/1,000 dilution. Anti-Rabbit IgG for IP Nano-secondary antibody (NBI01H) at 1/5,000 dilution was used for 1 hour at room temperature. Lane 1: HeLa cell lysate (input) Lane 2: HA722340 IP in HeLa cell lysate Lane 3: Rabbit IgG instead of HA722340 in HeLa cell lysate Blocking/Dilution buffer: 5% NFDM/TBST Exposure time: 5 seconds; ECL: K1802 |
Note: All products are “FOR RESEARCH USE ONLY AND ARE NOT INTENDED FOR DIAGNOSTIC OR THERAPEUTIC USE”.